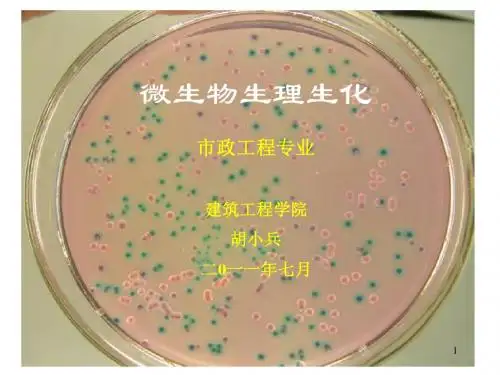

微生物生理学概论
- 格式:ppt
- 大小:28.24 MB
- 文档页数:7

绪论1.微生物生理学的研究对象与范围有哪些?研究对象:微生物生理学是研究微生物的正常功能和现象的科学,也就是研究微生物细胞的结构功能、生长繁殖、营养代谢、形态发生、遗传变异等活动中的生理规律。
研究范围:1.研究微生物细胞的重建方式与一般规律2.研究微生物与周围环境之间的关系3.研究微生物生理活动与人类的关系2.试叙微生物生理学研究中常用的技术与方法。
培养技术染色技术显微观察技术生化技术生物物理技术生物合成技术3. 您对21世纪微生物生理学的展望有哪些认识?1.微生物生理学的基础研究继续得到加强2.继续从微生物代谢产物中发现新的化合物、新的具有特殊功能的生物催化剂3.与其他学科实现更广泛的交叉4.在解决人类所面临的许多重大问题中,微生物生理学将发挥重要作用第一章微生物的显微结构和亚显微结构1.试叙原核细胞和真核细胞的区别。
原核生物真核生物核拟核真核核膜—+核仁—+染色体数 1 》1染色体组成DNADNA+组蛋白细胞分裂二分分裂有丝分裂减数分裂细胞器间体线粒体叶绿体细胞壁组成肽聚糖纤维素几丁质核糖体70S80S基因重组接合转化转导有性准性过程2.试叙鞭毛的结构与功能。
•鞭毛发源于细胞膜内侧的基粒上细胞壁为鞭毛的运动提供了支撑点。
G+和G-菌中,鞭毛结构有区别。
鞭毛:运动、具有抗原性•细菌的三种运动方式:细菌鞭毛的自由运动粘细菌的滑行运动螺旋体的伸缩运动3.试叙菌毛的结构与功能。
结构:菌毛是由菌毛蛋白组成的,菌毛至少十根以上,一般周生。
功能:粘附,与致病性有关4.试叙细胞壁的结构与功能。
G+ 比G- 细胞壁结构简单,G+细胞壁只有厚厚的一层肽聚糖物质,而G-除有一层薄薄的肽聚糖物质外,在外层还有一层脂质物质合并一起构成细胞壁。
功能:1、机械保护作用,抗渗透压,保持菌体形态;2、内外物质交换的屏障;3、与抗原性、致病性、对噬菌体的敏感性有关。
5.试叙细胞膜的结构与功能。
功能:1、作为细胞内外物质交换的屏障和介质,有选择性;2、能量交换的场所,与呼吸、光合作用3、有关的酶类、电子传递链位于膜上;4、传递信息;5、参与细胞壁的合成。

微生物生理学简介微生物生理学是研究微生物(包括细菌、真菌、病毒等)在生理上的活动和代谢过程的学科。
微生物在地球上广泛存在,并在各个生态系统中扮演着重要角色。
了解微生物生理学有助于我们理解微生物的生命活动和其与环境之间的相互关系。
本文将从微生物的生长、代谢、运动等方面介绍微生物生理学的基本知识。
微生物的生长微生物的生长是指微生物个体数量的增加。
微生物可以通过两种主要方式进行繁殖:有丝分裂和无丝分裂。
有丝分裂适用于真菌和一些原生动物,通过细胞核的分裂和细胞质的分裂来产生新的个体。
无丝分裂适用于细菌和病毒等微生物,在此过程中,微生物通过复制DNA并将其分配给新形成的细胞来繁殖。
微生物的生长受到一系列因素的影响,包括温度、pH值、营养物质和氧气含量等。
不同的微生物对这些环境因素的要求各不相同。
例如,嗜热菌可以在高温环境中生长,而嗜冷菌则适应于低温环境。
微生物的代谢微生物通过代谢产生能量和合成生物分子。
代谢过程可以分为两个主要类型:有氧代谢和厌氧代谢。
有氧代谢是指微生物在氧气存在的情况下进行的代谢过程,产生较多的能量。
厌氧代谢是指微生物在氧气缺乏的条件下进行的代谢过程,产生较少的能量。
微生物通过新陈代谢和合成代谢来维持生理功能。
新陈代谢是指分解有机物质以产生能量的过程,合成代谢是指合成微生物所需的有机物质和细胞组件的过程。
微生物的运动微生物可以有不同的运动方式,包括游动、滑动和极纤毛等。
游动是指微生物利用鞭毛或纤毛等结构在液体中进行活动。
滑动是指微生物利用纤毛或假足等结构在固体表面上移动。
极纤毛是一种很短的纤毛,存在于细菌和某些原生动物中,用于以一种像旋转的方式推动细胞。
微生物的运动与其环境之间的相互作用密切相关。
微生物通过感知环境中的化学物质浓度、光照和温度等刺激来调整自己的运动方式。
这种对环境的感知和反应既可以是积极的,也可以是消极的,有助于微生物适应不同的生态环境。
结论微生物生理学作为一个重要的学科,研究微生物在生理上的活动和代谢过程。




微生物学专业(理学硕士、博士) 微生物功能蛋白 植物病理学专业(农学硕士、博士) 植物病原物相互作用 分子植物病理学微生物学是生命科学中一门极其活跃、生命力强 大的学科,既是基础学科又是应用学科。
微生物学的 发展,促进了生命的自我复制、生命进化,生命分子 构成等重大理论研究。
生命科学的许多重大研究成果 都是以微生物为研究材料的。
由于微生物学的许多重 大发现,包括质粒载体、限制性内切酶、连接酶、反 转录酶等,才导致了DNA 重组技术和遗传工程的出 现,使整个生命科学翻开了新的一页。
微生物学在生 命科学中占有重要地位,对整个生命科学的发展做出 了巨大贡献,在生命科学的发展中起着先锋和奠基的 双重作用。
本课程为植物保护专业微生物方向的专业必 修课。
通过学习微生物的形态结构、生理生化、 生长繁殖、遗传变异、生态分布、传染免疫、分 类鉴定以及微生物与其他生物的相互关系及其多 样性,以及在工、农、医等方面的应用,使学生 牢固掌握微生物学的基本理论、基础知识和基本 技能,了解微生物的基本特征及其生命活动规 律,培养学生的实践能力和创新精神,为学生今 后的学习及工作实践打下宽厚的基础。
微生物学的教学环节主要采用课堂讲 授方式授课,辅以辅导答疑和考试。
同时 开设实验课,使学生掌握微生物学的基本 实 验 技 术 。
做 到 课 堂 讲 授 与 实 验 操作 并 重,以保证教学质量。
总学时:88; 授课:58; 实验:30 教 材: 李阜棣,胡正嘉《微生物学》(第六版) 中国农业出版社 参 考 书: 周德庆《微生物学》(第二版)1绪论 原核微生物 真核微生物 病毒 微生物营养 微生物营养、代谢 微生物生长 微生物遗传与变异 微生物遗传与变异 微生物生态、应用 微生物传染与免疫 微生物进化、分类鉴定4 8 6 8 2 4 4 4 2 8 4 2王振中 卓侃 王新荣 阮小蕾 王新荣 王新荣 王新荣 王新荣 王新荣 王新荣 王新荣 王新荣微生物学是研究微生物生命活动规律的 科学。


微生物生理学微生物生理学,简单来说就是研究微生物的生命活动和代谢规律。
微生物是一类生命活动丰富、功能多样的生物,对各种化合物都有代谢能力,常常作为重要的工业菌来使用。
微生物生理学研究更是应用广泛,如农业、医学、食品、环保等领域。
下面,我们从微生物的代谢入手,探讨一下微生物生理学的一些基本概念和应用。
第一部分微生物代谢微生物代谢是微生物生理学的核心之一。
代谢是生命活动的基本过程,包括有机物的分解与合成,能量的产生与利用等。
在微生物代谢中,可以分为两种类型,即可以在顺应郭中生存的化能型微生物和以化学反应为生存基础的化学型微生物。
1.1 化能型微生物化能型微生物,也叫做碳源化微生物,可以分解有机物质并利用氮气、二氧化碳等化合物产生大量的能量,从而完成其生存过程。
常见的化能型微生物有产酸菌、膜糖体菌等。
这些微生物能够利用糖类、脂肪、蛋白、醇等有机物质产生能量,产生的能量可以用于合成细胞组分或响应外界刺激。
此外,还可以利用无机物质进行能量代谢,例如硫化氢细菌可以利用硫化氢合成ATP。
1.2 化学型微生物化学型微生物,也叫做于外营养物质微生物,不依靠外界有机体大量提供生存必需物质,而是通过化学反应来获得维持基本功能的能量和生物分子。
最典型的例子是大多数甲烷杆菌,它们不依赖于外部有机体大量提供生命必需物质,而是利用甲烷和碳酸盐进行代谢反应,获得能量和所需化合物质。
与化能型微生物不同的是,化学型微生物更多的是通过化学反应来维持生命活动和代谢。
第二部分微生物生理学的应用微生物生理学的应用十分广泛,从食品工业到医学领域,都可以利用到微生物生理学知识。
下面,我们重点介绍其中几个应用。
2.1 食品工业微生物在食品工业中起着极其重要的作用。
酸奶、芝士、酱油等食品的生产离不开微生物的应用。
微生物可以发酵,产生酸、酸性物质、酵素、蛋白质等,根据不同的产品需要,制定不同的菌种和发酵条件,从而生产出不同的食品。
2.2 医学领域微生物在医学领域的应用十分广泛。

微⽣物⽣理学总结第⼆章微⽣物的结构和功能微⽣物⽣理学:是微⽣物学的分⽀学科,是从⽣理⽣化的⾓度研究微⽣物细胞的形态学结构和功能、新陈代谢、⽣长繁殖等微⽣物⽣命活动规律的学科。
细胞结构⾰兰⽒阳性菌细胞壁:由肽聚糖和磷壁酸组成⾰兰⽒阴性菌细胞壁外壁层:位于肽聚糖层的外部。
类脂A脂多糖: 核⼼多糖o-特异侧链包括: 脂蛋⽩蛋⽩质层: 基质蛋⽩外壁蛋⽩磷脂.内壁层:紧贴胞膜,仅由1-2层肽聚糖分⼦构成,占细胞壁⼲重5— 10%,⽆磷壁酸。
细胞壁的基本⾻架——肽聚糖肽聚糖:是由N—⼄酰胞壁酸(NAM)和N—⼄酰葡糖胺(NAG)以及少数氨基酸短肽链组成的亚单位聚合⽽成的⼤分⼦复合体。
肽聚糖单体:是由NAG 、NAM 、肽尾、肽桥构成。
青霉素(D-丙氨酰-D-丙氨酸的结构类似物,两者互相竞争转肽酶的活性中⼼):作⽤于肽聚糖肽桥的联结,即抑制肽聚糖的合成,故仅对⽣长着的菌有效,主要是G+菌。
⾰兰⽒染⾊原理:G+ 菌:细胞壁厚,肽聚糖含量⾼,交联度⼤,当⼄醇脱⾊时,肽聚糖因脱⽔⽽孔径缩⼩,故结晶紫-碘复合物被阻留在细胞内,细胞不能被酒精脱⾊,仍呈紫⾊。
G¯菌:肽聚糖层薄,交联松散,⼄醇脱⾊不能使其结构收缩,因其含脂量⾼,⼄醇将脂溶解,缝隙加⼤,结晶紫-碘复合物溶出细胞壁,酒精将细胞脱⾊,细胞⽆⾊,沙黄复染后呈红⾊。
古细菌细胞壁没有肽聚糖、胞壁酸和D-氨基酸,含有假太聚糖⾻架是以β-1,3糖苷键交替连接⽽成,缺壁细菌原⽣质体:⽤青霉素等抗⽣素或者溶菌酶处理G+菌⽽得到的去壁完整的球形体。
原⽣质球:⽤青霉素等抗⽣素或溶菌酶处理G-细菌⽽得到的去壁不完全的近球形体。
L型细菌:某些细菌在特定环境条件下因基因突变⽽产⽣的⽆壁类型。
在⼀定条件下L型细菌能发⽣回复突变⽽恢复为有壁的正常细菌。
⽀原体:在进化过程中天⽣⽆壁的原核微⽣物。
细胞质膜;:要由磷脂双分⼦层和蛋⽩质构成。
细菌细胞与真核细胞的质膜很相似,但不含胆固醇等甾醇细胞质及其内含物细胞质:是在细胞膜内除核区以外的⼀切半透明、胶体状、颗粒状物质的总称。

微生物生理学绪论一、微生物生理学的研究对象与范围有哪些?研究对象:微生物生理学是研究微生物的正常功能和现象的科学,也就是研究微生物细胞的结构功能、生长繁殖、营养代谢、形态发生、遗传变异等活动中的生理规律。
研究范围:1.研究微生物细胞的重建方式与一般规律。
2.研究微生物与周围环境之间的关系。
3.研究微生物生理活动与人类的关系。
二、试叙微生物生理学研究中常用的技术与方法。
1.培养技术:微生物的类群众多,且都要求适合于自身的培养环境,因而发展了多种多样的培养技术。
2.染色技术:染色技术构成了以染色反应为基础的细菌细胞化学。
细菌的每一基质都产生一个固定的染色反应,如我们要观察细胞的某一特殊构造,就需经过一特殊的染色。
3.显微观察技术:相差,暗视野,荧光和电子显微镜的观察技术(扫描、透射)。
4.生化技术:对细菌结构及其代谢产物、降解产物、合成产物进行的分离,纯化和分析的技术。
5.生物物理技术:测量细菌的能量和电泳性质时,用凝胶扩散沉降试验、免疫反应、酶活性等。
在免疫反应酶活性方法中,多使用光谱仪、质谱仪、各种层析、标记元素等。
6.生物合成技术:在生物合成中,多使用磁共振和顺磁共振、超速离心、超滤、聚葡聚糖凝胶柱层析、粘度计、旋光仪、比浊计、各种测压技术和分子放射自显影技术等。
三、您对21世纪微生物生理学的展望有哪些认识?吕文虎克(荷兰人,1632-1723)巴斯德(法国人,1822-1895)为微生物生理学奠定了坚实的基础。
柯赫(德国人,1843-1910)21世纪微生物生理学的展望:1.微生物生理学的基础研究继续得到加强。
2.继续从微生物代谢产物中发现新的化合物、新的具有特殊功能的生物催化剂。
3.与其他学科实现更广泛的交叉。
4.在解决人类所面临的许多重大问题中,微生物生理学将发挥重要作用。
四、试叙微生物生理学与其他学科的关系。
微生物生理的内容涉及分子生物学、细胞生物学、生物化学、动植物生理学、遗传学、免疫学以及微生物学等多种学科。